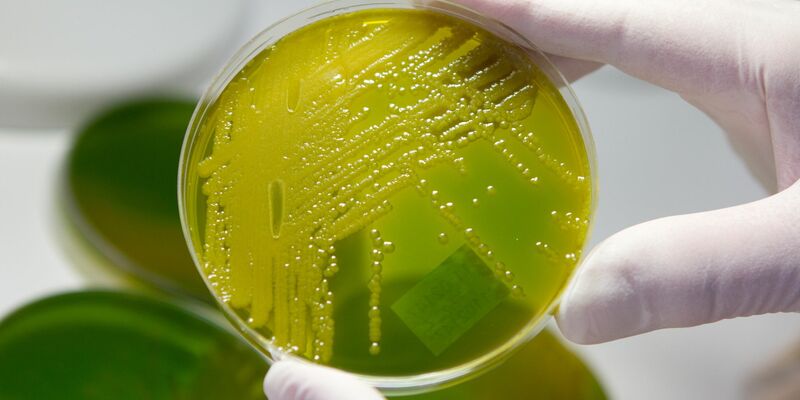
In Zwiebelmettwurst wurden die Bakterien nachgewiesen. (Archivbild)  - Foto: Matthias Bein/dpa-Zentralbild/dpa

Wegen Ehec-Gefahr ruft ein Hersteller Zwiebelmettwurst zurück.
30.08.2025 - 09:50:07Zwiebelmettwurst wegen Ehec-Gefahr zurückgerufen. In einer Charge wurden Erreger gefunden.
Die Schleizer Fleisch- und Wurstwaren GmbH ruft ihre Zwiebelmettwurst in der 500-Gramm-Packung zurück. In einer Charge mit dem Mindesthaltbarkeitsdatum 27.08. seien bestimmte toxinbildende Escherichia-coli-Bakterien (Ehec) nachgewiesen worden, teilte das Unternehmen am Freitag mit. Die Keime können bei Menschen schwere Erkrankungen auslösen. Vom Verzehr der Wurst wird dringend abgeraten.
Nach Angaben des Unternehmens war das Produkt in Baden-Württemberg, Hamburg, Mecklenburg-Vorpommern, Nordrhein-Westfalen, Sachsen-Anhalt, Brandenburg, Bayern, Hessen, Niedersachsen, Sachsen und Thüringen erhältlich. Kunden können die Zwiebelmettwurst laut Mitteilung im Handel abgeben und bekommen ihr Geld zurück.
Betroffenes Produkt
- Produkt: Schleizer Zwiebelmettwurst
- Verpackungseinheit: 500 Gramm
- Produktionsdatum: 11.08.2025
- Mindesthaltbarkeitsdatum: 27.08.2025
- Chargennummer: 133 (Kennzeichnung am Verschlussklipp)
- Hersteller: Schleizer Fleisch- und Wurstwaren GmbH, Industriestraße 2, 07907 Schleiz
Durchfall und Bauchkrämpfe
Ehec produzieren starke Zellgifte, die schwere Durchfallerkrankungen bis hin zu blutigen Durchfällen sowie das hämolytisch-urämische Syndrom (HUS) verursachen können, das zu Nierenversagen führen kann.
Kinder sind besonders gefährdet, weil ihr Immunsystem und ihre Organe noch nicht ausgereift sind. Auch bei Vorerkrankten und älteren Menschen kann der Verlauf gravierender sein. Vom Verzehr eines verunreinigten Lebensmittels bis zum Ausbruch der Erkrankung dauert es im Durchschnitt drei bis vier Tage.
Im Jahr 2011 hatte es einen großen Ehec-Ausbruch in Deutschland gegeben, rund 3.800 Erkrankungen wurden dabei erfasst, mehr als 50 Menschen starben. Als wahrscheinliche Ursache gelten verunreinigte Sprossen aus Ägypten importierter Bockshornkleesamen. In Mecklenburg-Vorpommern kam es zuletzt zu einer Häufung von Ehec-Infektionen, betroffen sind vor allem Kinder.